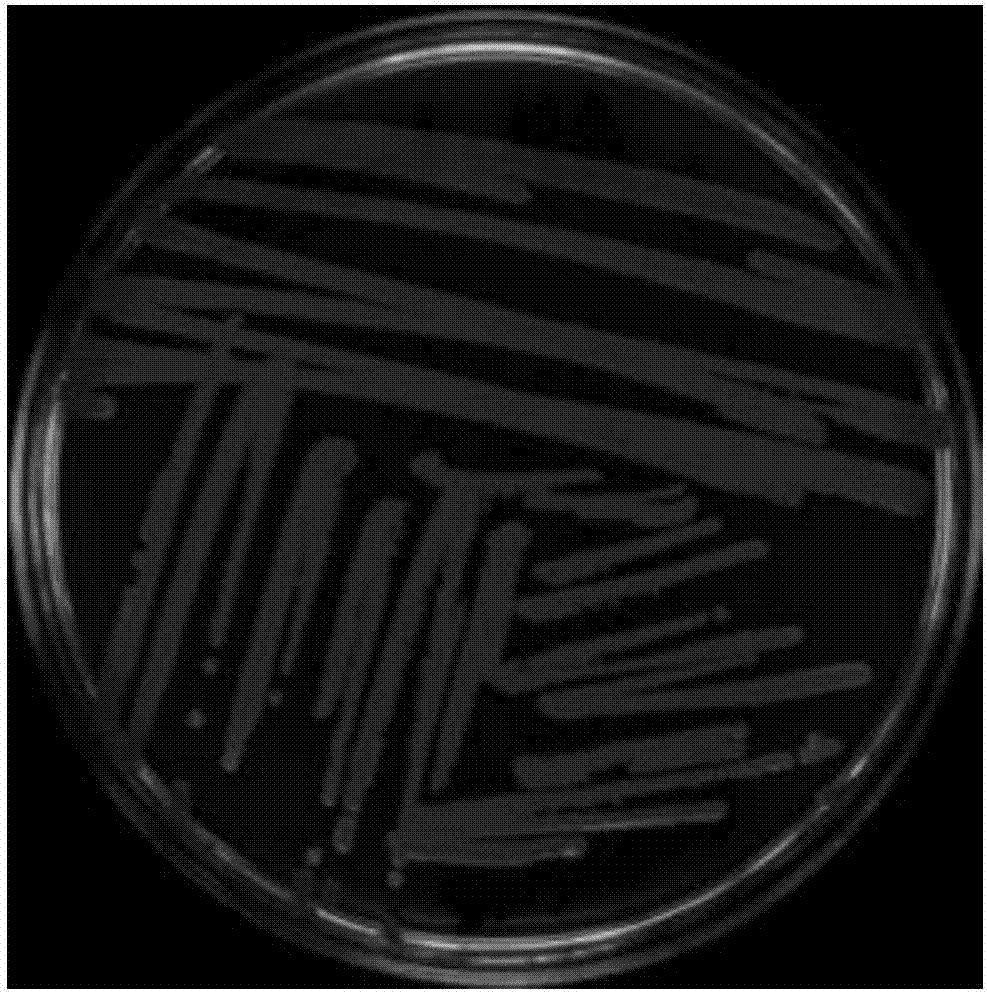
beat365官网中文_牺牲环境换经济增长？这个念头不能有！(图2)

- beat365官网中文_牺牲环境换经济增长?这个念头不能有!
- 林芝市:绿水青山美 生态红利来‘BEAT365’
- “BEAT365”生态环境部继续指导做好江苏响水天嘉宜化工有限公司“3;21”特别重大爆炸事故应对工作
- BEAT365|环卫――“美丽中国”的桥头堡
- beat365官网中文|禁止洋垃圾之后,我们自己的“垃圾”怎么办?
- 蓝色经济与全球海洋治理之减塑篇:绿动全城,源头减塑“beat365”
邮箱:admin@cqmhym.com
手机:17949016830
电话:092-16400933
地址:河南省郑州市鄠邑区国人大楼41号
beat365官网中文_牺牲环境换经济增长?这个念头不能有!
3月5日,习近平总书记在参与十三届全国人大二次会议内蒙古代表团审查会时特别强调,要维持强化生态文明建设的战略定力。维护和发展经济彻底谈是有机统一、相辅相成的。
无法因为经济发展遇上一点艰难,就开始动铺摊子上项目、以壮烈牺牲环境交换条件经济快速增长的念头,甚至想方设法突破生态维护红线。在我国经济由高速快速增长阶段改向高质量发展阶段过程中,污染防治和环境治理是必须横跨的一道最重要关口。总书记的讲话,在代表委员中引起反感回响。维持强化保护建设的定力,就是不挽回、不松劲、不开口子,更加无法突破生态维护红线。

因为污染更容易管理无以,一旦泊了劲了经常出现“纳抽屉”,那很多环境治理成果就不会前功尽弃。要构建经济高质量发展,就必需咬紧牙关,爬坡过坎,齐心协力横跨这道最重要关口。近年来的环境治理、预防污染,给大家的生活带给了哪些变化?与经济发展的关系是怎样的?咱们一起来讲出代表委员和专家的观点。
在成都远眺雪山,在北京云彩星空四川是天府之国,是长江上游生态屏障,四川的质量倍受社会注目。四川省厅厅长于会文代表说道,全省严肃贯彻落实党中央对建设生态文明的部署和拒绝,近年来成都平原的空气质量明显改善。2018年,全省的大气优良率超过了84.8%,同比提升了2.6个百分点。
水的优良率去年超过了88.5%,同比提升14.9个百分点。水、气的提高都比全国平均水平要低一些。
“四川沱江,去年也构建了十年来最差的水平,水质比上一年度提高了5倍。” 的提高,不仅反映在指标上,更好的是人民群众的切身感受。现在在四川有一个比蓝天白云更加高品位的,就是看雪山。从省会成都能无法看见雪山?答案是:能!成都西岭雪山。
“成都是世界唯一一个可以用肉眼看到5000米雪山的千万级人口大城市。最近有个名字叫‘在成都远眺雪山’的微信群尤其火,根据群主公布的信息,2018年,在成都看到雪山的日子共计56天,比2017年又多了6天。”于会文代表讲解,现在在成都看雪山,不仅是看的天数多,看的个数多,看的更加明晰,而且还全域可以看见雪山。统计数据表明,2018年,北京的蓝天数是将近4年以来比例最低的一年。
北京人的一个显著感觉,就是蓝天白云的日子更加多了。3月7日,在全国人大举办的记者会上,财政部的两位领导也谈及了北京蓝天的变化。财政部部长刘昆回应,他也有某种程度的感觉:“昨天晚上我回家的时候,看见满天的星斗,显然深感十分的感觉。
”财政部副部长刘伟,在财政部分管大气污染防治工作。刘伟说道:“我分管这块工作,我的心情每天随着PM2.5指标在平缓。
我也教导了习惯,2020-03-08 早上我一看,指标到了27,我快乐得不得了。前几天上了200,我还跟专业部门的同志通话。”“总的看,北京的PM2.5从89.5到58,再行到51,还是正处于一个较慢上升地下通道,上升速度之慢在国际上还是鲜有的。
” 部环境与经济政策研究中心主任吴舜泽说道。北京的蓝天。
提高空气必需持续用“药”提高,大家心里有感觉,但心里还不是很做事,实在稳定度不低、提高的脆弱性较强。从全国的情况来看,有很多的时候一遇上静稳,还是无法看见蓝天白云。
原因在于,现在的排放量还是多达了自净能力,遇上很差的天气,光靠“自净能力”就敢了。“现在的提高还没离开了老天爷协助,给力就好一些,不给力就劣一些。现在打污染防治攻坚战,正处于重复博弈论的拉锯战状态。
现在的提高还谈不上持续平稳,有可能一不小心就声浪。持续了解提高,必需标本兼治。” 于会文代表特别强调,坚守阵地、稳固成果,最重要的是逃跑原先的各项措施不放开,比如探讨重点时段和重点区域精准发力,用好保护专员公署的“尚方宝剑”,运用各种手段极力压制环境违法行为。
同时,下大气力调整产业结构、优化能源结构,推展构成绿色生产生活方式。近年来,山西省临汾市空气质量提高幅度显著,但空气质量名列在全国依然靠后,临汾市市长刘予强代表回应,临汾治污的任务依然很轻。今年,临汾将坚定信心,下定决心,极力扫除“煤炭倚赖”,树根理念、优布局、调结构、强劲管理、楚动员,以斗争精神打好蓝天保卫战。
“从道理上谈,要求2020-03-08 空气质量意味著等级优劣的是什么?是天,这是一个客观情况。我们常常讲有两个7:3,就是2020-03-08 空气质量的决定性因素,还有七成是老天爷;但是今年和去年比起,提高程度则是人的希望占到七成。” 吴舜泽说道。
“去年中央财政决定大气污染防治专项资金200亿元,这是2013年的4倍。在资金反对上,财政部是不予重点确保的。”刘伟说道,除了大力支持大气污染管理,财政部还通过其他专项资金400亿元左右,反对清洁能源开发利用、节能减排、新能源汽车推广应用等,这样综合施策来解决问题大气的问题。
今年中央财政决定大气污染防治资金,在去年200亿元的基础上,再行减少决定50亿元,快速增长25%。在这250亿元之外,另外还有350亿元是对水污染防治、土壤污染防治的投放,快速增长的幅度都是十分大的。捉环保本身就是捉发展“习近平总书记特别强调,无法因为经济发展遇上一点艰难,就开始动铺摊子上项目、以壮烈牺牲环境交换条件经济快速增长的念头,甚至想方设法突破生态维护红线。”于会文代表说道,“总书记的话说道到了大家心坎上。
从实践中看,积极开展环境治理越早、就越主动,阵痛期就不会越高,经济发展质量就不会越高。”代表委员们回应,恪守红线、严苛监管影响的是粗犷快速增长,以强化环保监管推展构成公平竞争秩序,是对高质量发展的最重要反对。环境治理需要造就绿色产业发展,是经济发展的最重要推动力。
2018年我国保护和环境治理业投资同比快速增长高达43%。以第三方管理、环境管家服务等为核心的现代环境服务产业体系,正在加快构成。
“我们是环境治理的受益者,根据极力打好污染防治攻坚战的拒绝,我们大力发展新能源,持续发展水电。短期看,火电装机规模受到一定影响,但从长远看,增进了企业可持续发展。”中国华电集团有限公司党组书记、董事长温枢刚刚代表说道,公司逃跑国家前进“煤改气”的机遇,大力发展清洁能源,拓展了发展新天地。
内蒙古风电场。刘予强代表指出,环境治理是高质量发展的题中理应之义,捉环保本身就是捉发展。
临汾调整产业结构,前进转型升级,希望回头绿色发展之路,就是要从源头上解决问题环境污染问题,减缓前进高质量发展。临汾治污的实践中解释,环境治理既能提高、增进经济高质量发展,同时也能解决问题老百姓身边的引人注目环境问题,增进社会人与自然平稳。

吴舜泽讲解,部早已对一手捉严苛规范执法人员、一手捉热情高效服务作出部署,特别强调要依法行政、依法前进,规范权利裁量权,做分类指导、精准施策。对地方既要有敦促和拒绝,又要有反对和帮扶。
推崇企业对环境监管的合理表达意见,强化对企业治污的指导协助,获取适当的技术和资金反对,协助企业制订环境治理解决方案。“我们早已行动起来,在惩办环境违法行为的同时,更为侧重对企业的精准服务,与企业构成良性对话。”于会文代表说道,去年以来,四川省厅10位厅领导对21个市州的环境治理实施包干服务。
本文关键词:beat365,BEAT365,beat365官网中文
本文来源:beat365-www.cqmhym.com
- 上一篇:林芝市:绿水青山美 生态红利来‘BEAT365’
- 下一篇:暂无



